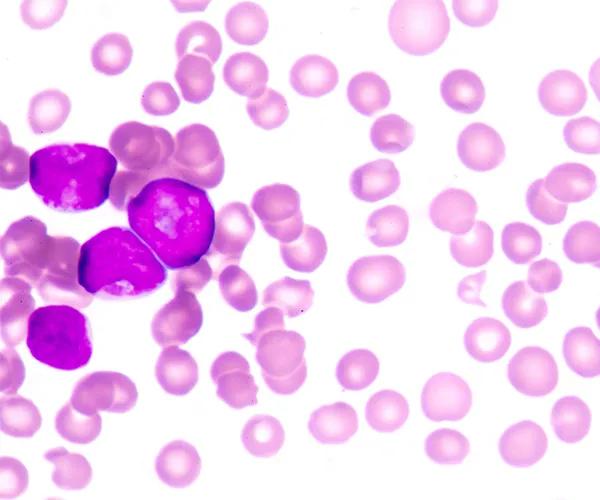

Our expansive PDX collection includes a wide range of patient-derived xenograft models representing diverse, clinically-relevant tumor types and genetic profiles. These models are available for in vivo efficacy testing through JAX® In Vivo Preclinical Services or can be distributed to your facility for research use.
Many of our PDX models are supported by comprehensive datasets, including gene expression and genomic data, standard of care treatment responses, and pathology images—all accessible via the Mouse Tumor Biology Database. Developed using highly immunodeficient NSG™ (005557) mice, our models preserve the biological characteristics of the original patient tumor and support the robust engraftment of challenging tumor types.
Explore additional models and detailed annotations through the Mouse Models of Human Cancer Database to find the right tools for your oncology or immuno-oncology research program.

Highly characterized, clinically-relevant models.
Fast study start-up and streamlined study designs.
The tumors in the PDX Live library are kept at low passage in live donor mice, ready to be shipped to you. Expedite your research further by having JAX Preclinical Services conduct the study for you. Our Preclinical Research Services offer optimized Patient Derived Xenograft (PDX) efficacy studies using the PDX Live™ library.

To advance preclinical evaluation of therapies for Acute Myeloid Leukemia (AML), JAX provides a diverse panel of AML Patient-Derived Xenograft (PDX) models that reflect a range of mutational landscapes and treatment backgrounds. Developed from the work of Townsend et al., these models are engrafted into the highly immunodeficient NSG™-SGM3 mouse strain (013062), which offers superior engraftment of human myeloid leukemia cells—making it an ideal platform for testing single agents or combination therapies.
The Mouse Models of Human Cancer Database (MMHCdb) is a comprehensive resource that provides detailed information on a wide variety of tumors. This database has integrated data on tumor frequency, incidence, genetics, and pathology, as well as patient information, making it a valuable tool for cancer research. The MMHCdb is freely accessible to all researchers without requiring login credentials or registration. Unlike other providers which require direct contact to access their databases, JAX offers immediate, unrestricted access to facilitate rapid research progress and collaboration across the scientific community.
Low-passage samples retain the heterogeneity and fidelity of human cancers. Engrafted tumors derived from a patient with a bladder urothelial papillary carcinoma demonstrate high concordance of tumor morphology, compared to low passage PDX tumor TM00015.

Figure A) Histology from the patient's primary tumor: High-grade urothelial carcinoma invading the bladder wall.

Figure B) Once engrafted, the histology for PDX model TM00015 at passage 1 also corresponds to high-rate urothelial carcinoma.

Figure C) Tumor cells of patient origin within the xenograft-stained positive using an anti-human antibody for Ki67.
Read more about the PDX Models and Services offerings at The Jackson Laboratory. Our PDX program provides tumor models at a lower passage than other providers, more accurately reflecting clinical samples than other PDX Resources. Learn more by viewing our PDX Models detail sheet.
Not what you're looking for?
Visit our Resource Hub